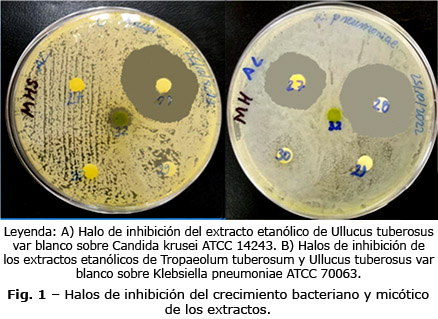

Artículo de investigación
Actividad biológica in vitro de los extractos acuosos y alcohólicos de tubérculos andinos
In vitro biological activity of aqueous and alcoholic extracts from Andean tubers
Pablo Djabayan Djibeyan1*
https://orcid.org/0000-0003-3342-5980
Mélany
Germania Cantos Jiménez2
https://orcid.org/0009-0001-6913-2218
María
Eugenia Lucena de Ustariz3
https://orcid.org/0000-0001-9120-345X
Marco
Vinicio Caiza Ruíz4
https://orcid.org/0000-0002-9181-5699
Francisco
Javier Ustariz Fajardo4
https://orcid.org/0000-0002-6423-9067
1Universidad
Nacional de Chimborazo. Facultad de Ciencias de la Salud. Grupo de Investigación
de Salud Pública. Riobamba, Ecuador.
2Ministerio
de Salud Pública. Distrito 06D04 Colta-Guamote. Chimborazo, Ecuador.
3Universidad
Nacional de Chimborazo. Facultad de Ciencias de la Salud. Grupo de Investigación
Análisis de Muestras Biológicas y Forenses. Riobamba, Ecuador.
4Universidad
Nacional de Chimborazo. Facultad de Ciencias de la Salud. Grupo de Investigación
de Salud Pública. Riobamba, Ecuador.
*Autor para la correspondencia. Correo electrónico: pdjabayan@unach.edu.ec; pdjabayan@gmail.com
Introducción:
La medicina ancestral ha utilizado plantas con cualidades medicinales para prevenir
y tratar enfermedades; aun cuando este tipo de investigaciones se han incrementado,
son escasos los estudios con tubérculos andinos.
Objetivo: Determinar la actividad biológica de extractos acuosos y etanólicos
de los tubérculos andinos Tropaeolum tuberosum (mashua) y Ullucus
tuberosus (melloco).
Métodos: La investigación fue experimental y se desarrolló in vitro.
La muestra estuvo constituida por 2 tubérculos andinos utilizados en la
medicina ancestral. Se aplicaron técnicas de extracción en medio acuoso y etanólico.
Los extractos fueron evaluados para determinar la actividad hemoaglutinante,
anticoagulante y antimicrobiana con cepas ATCC.
Resultados: Se demostró actividad hemoaglutinante en el extracto acuoso
de T. tuberosum sobre eritrocitos A. Todos los extractos acuosos mostraron
actividad anticoagulante, Tropaeolum tuberosum inhibió la actividad de
la coagulación sanguínea (vía intrínseca) con un TTPa> 300 seg. Tanto los
extractos acuosos y etanólicos exhibieron actividad antimicrobiana contra cepas
ATCC, Tropaeolum tuberosum inhibió el crecimiento de Staphylococcus
aureus 25923 con halos de 17 y 22 mm y Ullucus tuberosus (blanco)
con halos de 10 y 30 mm, respectivamente. Los extractos acuosos de Tropaeolum
tuberosum y Ullucus tuberosus (rojo) inhibieron el crecimiento de
Candida tropicalis 66029 con halos de 27 y 12 mm y respectivamente.
Conclusiones:
Determinada la actividad biológica, se evidencia que los tubérculos andinos
estudiados aglutinan eritrocitos humanos, específicamente eritrocitos del grupo
A, así mismo, capacidad de inhibir las proteínas plasmáticas de la coagulación
y de inhibir el crecimiento bacteriano y micótico de cepas ATTC.
Palabras clave: anticoagulantes; antibacterianos; antifúngicos; extractos vegetales; hemoaglutinación; tubérculos de plantas.
Introduction:
Ancestral medicine has used plants with medicinal qualities to prevent and treat
diseases, even though this type of research has increased, studies with Andean
tubers are scarce.
Objective: To determine the biological activity of
aqueous and ethanolic extracts of the Andean tubers Tropaeolum tuberosum
(mashua) and Ullucus tuberosus (melloco).
Methods: The research was experimental and was developed in vitro. The
sample consisted of 2 Andean tubers used in ancestral medicine. Extraction techniques
were applied in aqueous and ethanolic medium. The extracts were evaluated for
hemagglutinating, anticoagulant and antimicrobial activity with ATCC strains.
Results:
Hemagglutinating activity was demonstrated in the aqueous extract of T. tuberosum
on A erythrocyte. All aqueous extracts showed anticoagulant activity, Tropaeolum
tuberosum inhibited blood coagulation activity (intrinsic pathway) with
an aPTT> 300 sec. Both aqueous and ethanolic extracts exhibited antimicrobial
activity against ATCC strains, Tropaeolum tuberosum inhibited the growth
of Staphylococcus aureus 25923 with halos of 17 and 22 mm and Ullucus
tuberosus (white) with halos of 10 and 30 mm, respectively. The aqueous
extracts of Tropaeolum tuberosum and Ullucus tuberosus (red)
inhibited the growth of Candida tropicalis 66029 with halos of 27 and
12 mm, respectively.
Conclusions:
Once the biological activity was determined, it was evident that the Andean
tubers studied agglutinated human erythrocytes, specifically group A erythrocytes,
as well as the ability to inhibit plasma coagulation proteins and inhibit the
bacterial and fungal growth of ATTC strains.
Keywords: anticoagulants; antibacterials; antifungals; vegetable extracts; hemagglutination; plant tubers.
Recibido: 07/09/2023
Aprobado:
08/02/2024
INTRODUCCIÓN
La medicina tradicional en la actualidad es un soporte fundamental en la prestación de servicios de salud alrededor del mundo, su finalidad es prevenir y tratar ciertas enfermedades, particularmente las crónicas.(1)
La OMS(2,3,4) ha publicado informes sobre la resistencia antimicrobiana, pues los antibióticos han dejado de ser efectivos, causan miles de defunciones al año, cifra que podría elevarse a 10 millones para 2046, planteando un reto mundial para desarrollar nuevos antimicrobianos. En 2015 se estableció el Sistema Mundial de Vigilancia de la Resistencia a los Antimicrobianos (GLASS en inglés)(5) para monitorear la resistencia y el consumo de antimicrobianos. El informe(5) del año 2022 reportó que la resistencia fue principalmente por infecciones del torrente sanguíneo y tracto urinario.
Existe escasa evidencia científica del uso terapéutico de Tropaeolum tuberosum (mashua) y Ullucus tuberosus (melloco) para tratar y prevenir dolencias, sin embargo, la presencia de compuestos bioactivos en ellas respalda sus propiedades medicinales.(6) La actividad biológica de estos fitoquímicos podría ayudar en el tratamiento de enfermedades;(7) la mayoría de los medicamentos autorizados tienen origen natural, por lo tanto, los productos naturales siguen siendo fundamentales en el proceso de descubrimiento y desarrollo de nuevos medicamentos.(8)
Como son escasos los estudios que respaldan la actividad biológica de los tubérculos andinos, el objetivo de esta investigación es determinar la actividad hemoaglutinante, anticoagulante y antimicrobiana de los extractos de los tubérculos andinos Tropaeolum tuberosum (mashua) y Ullucus tuberosus (melloco).
MÉTODOS
La investigación fue experimental, in vitro; la población estuvo constituida por los tubérculos andinos inventariados en los mercados del Cantón Riobamba, Provincia de Chimborazo, Ecuador; se seleccionaron 2 especies que la medicina ancestral utiliza: Ullucus tuberosus(Melloco blanco, caramelo y rojo) y Tropaeolum tuberosum (Mashua amarillo). Los nombres científicos fueron consultados en la literatura científica publicada.(9)
Se tuvieron como variables: Dependiente, la actividad hemoaglutinante, anticoagulante y antimicrobiana. Independiente, las especies de tubérculos andinos seleccionados; e interviniente, el lugar de producción, altitud, condiciones de cultivo y época del año.
Preparación de los tubérculos andinos para la obtención de extractos
Los tubérculos fueron lavados con agua corriente, se enjuagaron con agua destilada, se escurrieron para secarlos; luego fueron cortados con cáscara y sometidos al proceso de extracción acuosa. Para el proceso de extracción etanólica los tubérculos limpios y secos se rallaron, el material rallado fue secado en estufa a 45 °C y pulverizado con un molino eléctrico.
Métodos de extracción
Extracción en solución salina fisiológica (SSF) estéril
El material utilizado fue esterilizado en autoclave a una temperatura de 121 °C con 15 psi de presión, por 15 minutos; 50 g de cada tubérculo fue licuado con 20 mL de SSF estéril, colocado en envases de plástico con tapa de rosca e incubado a 4°C por 24 horas, para extraer lectinas por infusión en frío.(10) La mezcla fue filtrada y centrifugada a 6000 r.p.m. por 15 minutos; el sobrenadante fue colectado en tubos plásticos cónicos con tapa y congelado a -20 °C.
Extracción por maceración con etanol al 96 %
De cada especie, 25 g fueron deshidratados y pulverizados en un molino eléctrico de cuchilla y colocados en frascos de vidrio con tapa hermética. Se les adicionó 100 mL de etanol al 96 %; la mezcla fue agitada cada 24 h por 7 días y filtrada utilizando papel filtro Whatman No.40. El filtrado colocado en un matraz de destilación se evaporó a una presión de vacío de 113 mbar con baño de maría a 60 °C. Evaporado el solvente, el extracto fue recuperado adicionando 5 mL de dimetilsulfóxido (DMSO) al 99,99 %, alícuotas de 1 mL en tubos Eppendorf se prepararon y conservaron a 4 °C.(11)
Actividad hemoaglutinante
Preparación de las suspensiones de eritrocitos nativos
Cinco (5) mL de sangre A, B y O obtenida de 3 donantes voluntarios sanos, 2 mujeres y 1 hombre, mayores de edad, que otorgaron su consentimiento informado. Fueron diluidos cada uno con 10 mL de SSF estéril y centrifugadas a 4000 r.p.m. por 5 minutos, el sobrenadante fue descartado, el procedimiento repetido 3 veces para eliminar interferentes. Luego, 1 mL de cada paquete de eritrocitos lavados fue diluido con 19 mL de SSF, para obtener una suspensión de eritrocitos, aproximadamente, al 5 %.(10)
Evaluación de la actividad hemoaglutinante
De cada extracto acuoso 0,1 mL y 0,1 mL de cada suspensión de eritrocitos al 5 %, se mezclaron en tubos de ensayo, se incubaron a temperatura ambiente por 30 minutos y luego centrifugados a 4000 r.p.m. por 1 min, el grado de aglutinación fue registrado de acuerdo con el esquema propuesto por Boorman y otros:(12) (4+)= muy fuerte aglutinación; (3+)= fuerte aglutinación; (2+)= moderada aglutinación; (1+)= débil aglutinación; (½+)= muy débil aglutinación; (0+)= suspensión de eritrocitos no aglutinado y (H) hemólisis.(12)
Títulos de hemoaglutinación
Se estimó mediante una dilución doble seriada con SSF estéril de cada extracto acuoso, con un volumen final de 0,1 mL en cada tubo a los que se agregó 0,1 mL de eritrocito de cada grupo sanguíneo respectivamente, siguiendo el procedimiento descrito para la hemoaglutinación, el título correspondió a la última dilución en la cual se detectó aglutinación.
Actividad anticoagulante
Preparación del pool de plasma citratado
El plasma humano citratado de 5 donantes voluntarios sanos, 3 mujeres y 2 hombres mayores de edad, que otorgaron su consentimiento informado, se mezcló un pool de plasma y alícuotas de 1 mL en tubos Eppendorf conservados a -20 °C.
Tiempo de protrombina (TP) de la mezcla plasma citratado y extractos acuosos
El TP, estimado según instrucciones técnicas del fabricante Pacific Hemostasis® y del Instituto de Normas Clínicas y de Laboratorio (CLSI ),(13) utilizando el reactivo Tromboplastina D. Con la finalidad de corregir el efecto dilución se mezcló 100 µL del pool de plasma citratado, con 100 µL de SSF, el valor del TP obtenido aplicando la técnica, se tomó como referencia, la prueba se realizó por triplicado.
Tiempo de tromboplastina parcial activado (TTPa) de la mezcla del plasma citratado y los extractos acuosos
El TTPa, estimado según instrucciones técnicas del fabricante Pacific Hemostasis® y del Instituto de Normas Clínicas y de Laboratorio (CLSI),(13) utilizaron el reactivo ATTP-XL-ácido elágico y el cloruro de Calcio (CaCl2) 0,02 M. Con la finalidad de corregir el efecto dilución se mezcló 100 µL del pool de plasma citratado, con 100 µL de SSF, el valor del TTPa obtenido y aplicaron la técnica, se tomó como referencia, la prueba se realizó por triplicado.
Actividad antimicrobiana
Método de difusión en agar para la actividad antimicrobiana
Aplicando la técnica de Kirby Bauer(14) y del CLSI,(15) se evaluó la actividad antimicrobiana contra cepas ATCC bacterianas grampositivas (Enterococcus faecalis 29212 y Staphylococcus aureus 25923, gramnegativas (Escherichia coli 25922, Klebsiella pneumoniae 70063 y Proteus mirabilis 25933) y micóticas del género Candida (C. albicans 1023, C. tropicalis 66029, C. krusei 14243 y C. glabrata 4843). Se prepararon inóculos bacterianos a 1,5 x 10 8 UFC/mL con el patrón de turbidez 0,5 de McFarland e inóculos micóticos a 3,0 x 10 8 UFC/mL con el patrón de turbidez 1,0 de McFarland,(11) inoculando placas de Petri con agar Müeller Hinton y agar Sabouraud Dextrosa azul de metileno respectivamente, discos estériles de 6 mm de diámetro y 2 mm de grosor impregnados con los extractos acuosos y etanólicos y discos estériles con antibióticos, antimicóticos y con SSF estéril como controles que fueron colocados equidistantemente en las placas, que se incubaron a 37 ºC por 24 horas para las bacterias y 48 horas para las levaduras, los halos de inhibición del crecimiento microbiano se midió con un escalímetro bajo lupa en milímetros.
Análisis estadístico
Este análisis de varianza y comparación de media utilizando el método de Tukey (95 % de confianza) se realizó mediante el software estadístico Minitab® de MiniTab Inc. PA, EE. UU. para evaluar las diferencias significativas en el estudio de la actividad antimicrobiana; para ello se realizaron comparaciones entre los valores de la media aritmética de los halos de inhibición del crecimiento microbiano, obtenidos por la acción de los diferentes extracto y los valores de la media aritmética de los halos de inhibición del crecimiento microbiano de los controles positivos utilizados, que fueron aplicados sobre cada especie microbiana ATCC, proporcionando una evaluación detallada de la eficacia antimicrobiana de los diferentes extractos.
RESULTADOS
Actividad hemoaglutinante
Evaluación de la actividad hemoaglutinante
El extracto acuoso de T. tuberosum exhibió una fitoaglutinina capaz de aglutinar fuerte y selectivamente glóbulos rojos A (4+), mientras que U. tuberosus exhibió una fitohemolisina (H) contra los 3 grupos sanguíneos luego de 18 horas de incubación.
Título de hemoaglutinación
El extracto acuoso de Tropaeolum tuberosum (mashua) mostró aglutinación hasta la dilución 1/8, por lo tanto, el título fue de 8 valor que corresponde al inverso de la última dilución en la que hubo actividad, lo que indica una concentración baja de la fitoaglutinina.
Actividad anticoagulante
TP y TTPa del plasma citratado + el extracto de las especies de tubérculos seleccionados
El TP evidenció que Ullucus tuberosus (rojo) posee actividad procoagulante discreta al acortar el TP (20 s) con relación al valor control (23+/-1), los otros extractos no mostraron actividad. El TTPa reveló que Ullucus tuberosus (blanco, caramelo y rojo) posee actividad anticoagulante inhibiendo parcialmente la actividad de la coagulación de la vía intrínseca y común, alargando el TTPa con valores de 71, 67 y 101 s respectivamente con relación al valor control (32+/-2), en cambio Tropaeolum tuberosum inhibió totalmente la actividad de la coagulación de la vía intrínseca y común con un TTPa que superó los > 300 s.
Actividad antimicrobiana
Método de difusión en agar para la actividad antimicrobiana
El extracto acuoso de Tropaeolum tuberosum inhibió solo el crecimiento S. aureus y Klebsiella pneumoniae con halos de menor diámetro respecto del control con diferencia estadística significativa (p< 0,05). El extracto etanólico inhibió el crecimiento de todas las bacterias, contra Escherichia coli y Enterococcus faecalis con halos de mayor diámetro respecto del control con diferencia estadística significativa (p< 0,05) y halos similares al control contra Staphylococcus aureus, Klebsiella pneumoniaey Proteus mirabilis con diferencia estadística no significativa (p> 0,05).
El extracto acuoso de Ullucus tuberosus blanco y caramelo inhibieron el crecimiento de todas las bacterias con halos de menor diámetro respecto del control con diferencia estadística significativa (p< 0,05), excepto la variedad caramelo que no inhibió el crecimiento de Proteus mirabilis; los extractos etanólicos de Ullucus tuberosus inhibieron el crecimiento de todas las bacterias, con halos de mayor diámetro contra Escherichia coli y Enterococcus faecalis respecto del control y de menor diámetro en la variedad rojo contra S. aureus con diferencia estadística significativa (p< 0,05), excepto la variedad rojo que no inhibió el crecimiento de E. faecalis; además halos similares en diámetro al control con diferencia estadística no significativa (p> 0,05) contra S. aureus, K. pneumoniaey P. mirabilis (tabla 1, Fig. 1).
El extracto acuoso de Tropaeolum tuberosum inhibió el crecimiento de Candida albicans y Candida. tropicalis con halos de menor diámetro y diferencia estadística significativa (p< 0,05) respecto del control. El extracto acuoso de Ullucus tuberosus variedades blanco, caramelo y rojo solo inhibieron el crecimiento de C. tropicalis con halos de menor diámetro y diferencia estadística significativa (p< 0,05). Los extractos etanólicos no mostraron poseer actividad, con excepción de Ullucus tuberosus variedad blanco que inhibió el crecimiento de Candida krusei con halo de menor diámetro y una diferencia estadística significativa (p< 0,05) respecto del control (tabla 2, Fig. 1).
DISCUSIÓN
La actividad hemoaglutinante evidenció que Tropaeolum tuberosum aglutinó únicamente eritrocitos A, entonces posee una lectina específica que se une a N-acetil-galactosamina (GalNAc), lo cual difiere con lo reportado por Aguas y otros,(16) en el 2019, que no la evidencian. Ullucus tuberosus no mostró actividad hemolizante, lo cual difiere de lo reportado por Silva y otros(17) que reportan actividad hemoaglutinante, discrepancias debidas probablemente a variables intervinientes, por otra parte, fue reportada una débil actividad específica para eritrocitos A en la variedad roja, actividad hemolizante en la caramelo y ninguna en la amarilla.(18) Esta actividad ratifica el estudio de Cheung y otros(19) en 2018, que destacan el potencial de los compuestos bioactivos para investigaciones biomédicas.
El TP no evidenció actividad en los extractos de ambos tubérculos, lo cual difiere con Djabayan y otros(18) que reportan actividad anticoagulante discreta de la vía extrínseca. El TTPareveló actividad anticoagulante parcial en Ullucus tuberosus y total en Tropaeolum tuberosum (TTPa> 300 s), lo que coincide con Chang y otros,(20) quienes reportan la misma actividad en el tubérculo Corydalis ambigua. Mientras que Djabayan y otros(18) informaron actividad procoagulante por acortamiento del TTPa, discrepancia que requiere ser resuelta con un estudio comparativo.
La actividad antibacteriana en extractos acuosos reveló inhibición del crecimiento de S. aureus y K. pneumoniae en Tropaeolum tuberosum y diferencias estadísticas significativas. En cambio, Ullucus tuberosus variedad blanco y caramelo inhibieron a todas las bacterias estudiadas excepto variedad caramelo que no inhibió a P. mirabilis, lo que coincide con Djabayan y otros,(18) Mejía y otros,(21) y Silva y otros.(17) Los extractos etanólicos de ambas especies inhibieron el crecimiento de las bacterias estudiadas, con diferencia estadística significativa en Tropaeolum tuberosum, resalta la inhibición de E. coli y E. faecalis con un halo mayor que Amikacina y de S. aureus, K. pneumoniae y P. mirabilis con estadística no significativa pero halos de inhibición muy similares a los antibióticos control que ratifican la presencia de un metabolito de amplio espectro, que requiere ser identificado mediante estudios fitoquímicos.
Los extractos etanólicos de Ullucus tuberosus inhibieron el crecimiento de todas las bacterias utilizadas la mayoría con diferencia estadística significativa, excepto U. tuberosus (rojo) que no mostró actividad contra E. faecalis, resalta U. tuberosus (blanco y caramelo) que inhibieron a E. faecalis, S. aureus, K. pneumoniae y P. mirabilis con diferencia estadística no significativa y halos de inhibición similares e incluso mayores a los antibióticos controles.
La actividad antimicótica de los extractos acuosos de T. tuberosum y U. tuberosus reveló actividad con diferencia estadística significativa atribuible a una lectina, ya que los extractos etanólicos de ambas especies no mostraron esta actividad, dado que los solventes orgánicos desnaturalizan a las lectinas, excepto en U. tuberosus (blanco) que inhibió el crecimiento de C. krusei, lo que no ocurrió con el extracto acuoso, tal vez por encontrarse en una concentración baja.
En este sentido, se coincide en afirmar que la actividad antimicrobiana de especies vegetales son una alternativa para obtener biofármacos;(22,23) por ejemplo, la actividad de T. tuberosum (mashua) puede deberse al contenido de isotiocianatos, que poseen efectos antibacterianos y antifúngicos importantes.(24,25,26)
Se concluye que: T. tuberosum posee actividad hemoaglutinante específica contra eritrocitos humanos A y U. tuberosus posee actividad hemolítica contra los grupos sanguíneos; hay actividad anticoagulante contra las proteínas plasmáticas de la coagulación de la vía intrínseca y común en T. tuberosum; hay actividad antibacteriana in vitro en los extractos acuosos y etanólicos, pero mayor en los extractos etanólicos y actividad antimicótica en todos los extractos acuosos frente a diferentes especies del género Candida.
Agradecimientos
A la Universidad Nacional de Chimborazo (UNACH), por el apoyo recibido en el proyecto de investigación N°021-2020-DIR.INV aprobado y financiado según Resolución N°143-CIV-07-08-2020 y por el uso de las instalaciones y equipos de los laboratorios de la Facultad de Ciencias de la Salud. Un agradecimiento especial a la Ing. Eliana de la Torre por su colaboración durante la fase experimental del proyecto.
REFERENCIAS BIBLIOGRÁFICAS
1. OMS-Organización Mundial de la Salud. Estrategia de la OMS sobre medicina tradicional. 2014-2023. [Internet]. Ginebra: Biblioteca de la OMS; 2013. [acceso: 25/05/2023]. Disponible en: https://iris.who.int/bitstream/handle/10665/95008/9789243506098_spa.pdf?sequence=1
2. OPS/OMS Organización Panamericana de la Salud. Resistencia a los antimicrobianos. [Internet]. Washington, DC: Programas e iniciativas; 2019. [acceso: 25/05/2023]. Disponible en: https://www.paho.org/es/temas/resistencia-antimicrobianos
3. OMS-Organización Mundial de la Salud. Resistencia a los antibióticos. [Internet]. Ginebra: Centro de Prensa; 2020. [acceso: 25/05/2023]. Disponible en: https://www.who.int/es/news-room/fact-sheets/detail/antibiotic-resistance
4. OPS/OMS-Organización Panamericana de la Salud. La resistencia antimicrobiana pone en riesgo la salud. [Internet]. Washington, DC: Noticias; 2021. [acceso: 25/05/2023]. Disponible en: https://www.paho.org/es/noticias/3-3-2021-resistencia-antimicrobiana-pone-riesgo-salud-mundial
5. OMS-Organización Mundial de la Salud. Global antimicrobial resistance and use surveillance system (GLASS) report 2022. [Internet]. Ginebra: Reporte; 2022. [acceso: 16/10/2023]. Disponible en: https://iris.who.int/bitstream/handle/10665/364996/9789240062702-eng.pdf?sequence=1
6. Arteaga-Cano D, Chacón-Calvo L, Samamé-Herrera V, Valverde-Cerna D, Paucar-Menacho LM. Mashua (Tropaeolum tuberosum): Composición nutricional, características químicas, compuestos bioactivos y propiedades beneficiosas para la salud. Agroind sci. 2022;2(1):95-101. DOI: 10.17268/agroind.sci.2022.01.12
7. Apaza Ticona L, Tena Pérez V, Bermejo Benito P. Local/traditional uses, secondary metabolites and biological activities of Mashua ( Tropaeolum tuberosum Ruíz & Pavón). J Ethnopharmacol. 2020;247:1-19. DOI: 10.1016/j.jep.2019.112152
8. Newman DJ, Cragg GM. Natural Products as Sources of New Drugs from 1981 to 2014. J Nat Prod. 2016;79(3):629-661. DOI: 10.1021/acs.jnatprod.5b01055
9. King SR, Gershoff SN. Nutritional evaluation of three underexploited Andean tubers: Oxalis tuberosa (Oxalidaceae), Ullucus tuberosus (Basellaceae), and Tropaeolum tuberosum (Tropaeolaceae). Economic Botany. 1987;41:503-511. [acceso: 25/05/2023]. Disponible en: https://link.springer.com/article/10.1007/BF02908144
10. Djabayan-Djibeyan P, Carpenter B, Medina-Ramírez G, Andueza-Leal F, León-Leal A, Djabayan-Russo A, et al. Cold Steeping Infusion, a Novel Lectin Extraction Technique for the Isolation, Purification and Partial Characterization of Lectins from the Green Venezuelan Marine Alga Caulerpa serrulata . Nat Prod Commun. 2018;13(12): 1715-1719. DOI: 10.1177/1934578X1801301233
11. Villarreal-Rivas S, Rojas-Fermin L, Lárez R, Torres M, Díaz C, Lucena de Ustáriz M, Carmona J. Caracterización química y actividad antimicrobiana de los componentes volátiles de Eucalyptus de dos especies de Venezuela. Rev Colomb Cienc Quim Farm. 2023;52(1):91-106 DOI: 10.15446/rcciquifa.v52n1.109361
12. Boorman KE, Dodd BE, Lincoln PJ. Blood Group Serology-Theory, Techniques, Practical Applications. 5th. Ed. London: Churchill Levingstone; 1977.
13. Adcock DM, Hoefner DM, Kottke-Marchant K, Marlar RA, Szamosi DI, Warunek DJ. Collection, Transport and Processing of Blood Specimens for Testing Plasma-Based Coagulation and Molecular Haemostasis Assays; Approved Guideline. 5 th ed. USA: Clinical and Laboratory Standards Institute (CLSI) Document H21-A5; 2008 [acceso:21/06/2023]. Disponible en: https://clsi.org/standards/products/hematology/documents/h21/
14. Bauer AW, Kirby WMM, Sherris JC, Turck M. Antibiotic susceptibility testing by a standardized single disk method. AJCP. 1966;45(4):493-496. DOI: 10.1093/ajcp/45.4_ts.493
15. Lewis-II JS, Weinstein MP, Bobenchik AM, Campeau S, Cullen SK, Dingle T, et al. Performance Standards for Antimicrobial Susceptibility Testing, 33 th ed. USA: Clinical and Laboratory Standards Institute (CLSI) supplement M100 Microbiology; 2023 [acceso:21/06/2023]. Disponible en: https://clsi.org/standards/products/microbiology/documents/m100/
16. Aguas-Salazar DA, Djabayan-Djibeyan P. Acción hemoaglutinante, anticoagulante y antimicrobiana obtenidas de los tubérculos andinos; [Tesis de Pregrado] Riobamba: Universidad Nacional de Chimborazo; 2019 [acceso: 21/06/2023]. Disponible en: http://dspace.unach.edu.ec/handle/51000/9910
17. Silva-Guadalupe JM, Medina-Ramírez GE. Evaluación de la actividad antibacteriana y hemoaglutinante de los extractos de Solanum phureja , Tropaeolum tuberosum, Oxalis tuberosa y Ullucus tuberosus ; [Tesis de Pregrado] Riobamba: Escuela Superior Politécnica de Chimborazo; 2018. [acceso: 21/06/2023]. Disponible en: http://dspace.espoch.edu.ec/handle/123456789/8833
18. Djabayan-Djibeyan P, González-Ramírez LC, Lucena de Ustariz ME, Valarezo-García C. Aislamiento y actividad biológica de lectinas obtenidas de semillas de frutas, granos y tubérculos de plantas andinas. Inf Tecnol. 2022;33(2):21-36. DOI: 10.4067/s0718-07642022000200021
19. Cheung RCF, Wong JH, Ng TB, Naude R, Rolka K, Tse R, et al. Tuber Lectins with Potentially Exploitable Bioactivities. Curr Med Chem. 2018;25(42):5986-6001. DOI: 10.2174/0929867325666180517095308
20. Chang S, Yang Z, Han N, Li, Z, Yin J. The antithrombotic, anticoagulant activity and toxicity research of ambinine, an alkaloid from the tuber of Corydalis ambigua var. amurensis. RTP. 2018; 95:175-181. DOI: 10.1016/j.yrtph.2018.03.004
21. Mejía-Lotero FM, Salcedo-Gil JE, Vargas-Londoño S, Serna-Jiménez JA, Torres- Valenzuela LS. Capacidad antioxidante y antimicrobiana de tubérculos andinos ( Tropaeolum tuberosum y Ullucus tuberosus). Revista U.D.C.A. 2018; 21(2):449-456. DOI: 10.31910/rudca.v21.n2.2018.1083
22. Silva-Correa CR, Pazo-Medina GI, Villarreal-La Torre VE, Calderón-Peña AA, Aspajo-Villalaz CL, Cruzado-Razco JL, et al. Wound healing activity of Tropaeolum tuberosum-based topical formulations in mice. Vet World. 2022;15(2):390-396. DOI: 10.14202/vetworld.2022.390-396
23. Apaza Ticona L, Tena Pérez V, Bermejo Benito P. Local/traditional uses, secondary metabolites and biological activities of Mashua ( Tropaeolum tuberosum Ruíz & Pavón). J Ethnopharmacol. 2020;247:1-19. DOI: 10.1016/j.jep.2019.112152
24. Apaza Ticona L, Rumbero Sánchez Á, Orozco Gonzáles Ó, Ortega Doménech M. Antimicrobial compounds isolated from Tropaeolum tuberosum. Nat Prod Res. 2020;35(22):4698-4702. DOI: 10.1080/14786419.2019.1710700
25. Lim TK. Tropaeolum tuberosum. En: Edible Medicinal and Non-Medicinal Plants. Springer, Cham. 2016 [acceso: 28/06/2023]. Disponible en: https://link.springer.com/chapter/10.1007/978-3-319-26065-5_3
26. Morillo AC, Morillo Y, Tovar YL. Caracterización molecular de cubios (Tropaeolum tuberosum Ruíz y Pavón) en el departamento de Boyacá. Rev Cienc Agr. 2016;33(2):32-42. DOI: 10.22267/rcia.163302.50
Conflictos de interés
Los autores declaran no tener conflicto de interés en la presente investigación.
Contribuciones de los autores
Conceptualización: Pablo Djabayan Djibeyan, Mélany Germania Cantos Jiménez.
Curación
de datos: Mélany Germania Cantos Jiménez, Marco Vinicio Caiza Ruíz.
Análisis
formal: Mélany Germania Cantos Jiménez, María Eugenia Lucena de Ustariz.
Investigación:
Pablo Djabayan Djibeyan, Mélany Germania Cantos Jiménez, María Eugenia Lucena
de Ustariz.
Metodología:
Pablo Djabayan Djibeyan, Mélany Germania Cantos Jiménez, María Eugenia Lucena
de Ustariz.
Administración
del proyecto: Pablo Djabayan Djibeyan.
Recursos
materiales: Pablo Djabayan Djibeyan, Mélany Germania Cantos Jiménez, Francisco
Javier Ustariz Fajardo.
Supervisión:
Pablo Djabayan Djibeyan, María Eugenia Lucena de Ustariz.
Visualización:
Pablo Djabayan Djibeyan, Mélany Germania Cantos Jiménez.
Redacción-borrador
original: Pablo Djabayan Djibeyan, Mélany Germania Cantos Jiménez, Francisco
Javier Ustariz Fajardo.
Redacción-revisión
y edición: Pablo Djabayan Djibeyan, Mélany Germania Cantos Jiménez, María
Eugenia Lucena de Ustariz, Marco Vinicio Caiza Ruíz, Francisco Javier Ustariz
Fajardo.